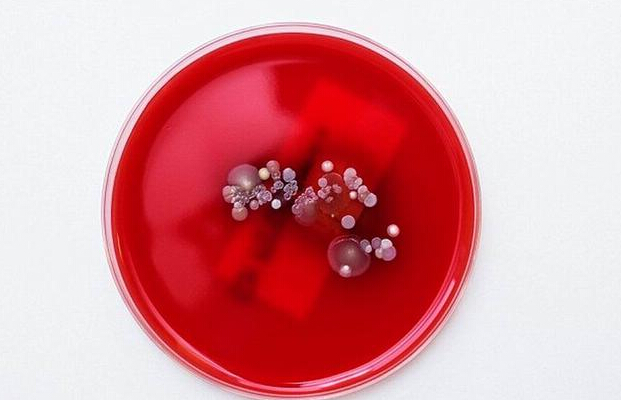

最新研究顯示,細菌可以模擬“微型生物發電站”,未來對智能手機等小型電子設備提供電能。
騰訊科學訊 據英國每日郵報報道,通常人們是不會喜歡細菌的,它們爬行在食物上,或者寄生在家中,但目前科學家最新研究表明,未來細菌將幫助我們對手機充電。
科學家模擬實驗顯示,細菌的自然運動產生動能可以采集利用,作為微型“風力發電廠”。他們認為,細菌也可以對智能手機充電。這項技術可在微型等級產生能量,如果得以廣泛應用,將具有深遠意義,有助于解決人類日益增長的能量危機。
英國牛津大學研究人員使用計算機模擬證實細菌作為一種密集活躍物質,通過組織利用可使圓柱形轉子運行,可以提供一種穩定的動力源。他們指出,生物驅動發電站未來有一天將成為微型發動機,適用于自組裝和自供電的小型人造電設備,例如:智能手機或者麥克風。
牛津大學物理系泰勒-申德魯克(Tyler Shendruk)博士說:“生產千兆瓦級電能具有一定的挑戰,發現和有效利用微觀等級發電也有一定難度。一種潛在的方法是對微型機械提供少量動能,直接在細菌懸液采集能量。”目前這項最新研究報告發表在近期出版的《科學》雜志上。
密集細菌懸液是一種典型的活性液體,該液體流動方式是自然的。雖然游動中的細菌能夠群游,驅動無序液體流動,但它們通常過于混亂無序,難以提取任何有用的能量形式。目前研究人員將64個微型轉子構成的一個晶格放入細菌懸液,發現細菌能夠自發地組織在一起,使鄰近轉子開始以相反方向旋轉,這讓人們聯想到一種簡單結構的風力發電裝置。
申德魯克博士解釋稱,令人吃驚的是,我們沒有預設計微型齒輪狀渦輪,這些轉子能夠自組裝成一種細菌風力發電裝置。當我們在細菌湍流中的一個單個轉子,它被隨機地“踢開”,當我們在細菌懸液中放置一批轉子時,它們會突然形成一種規律性模式,同時鄰近轉子會以相反的方向旋轉。
研究報告合著作者、阿敏-多斯特莫哈馬迪(Amin Doostmohammadi)博士稱,從生物系統獲得少量機械能量是非常寶貴的,因為它并不需要輸入功率,僅使用內部生物化學過程來實現移動。
著名學者朱莉婭-約曼斯(Julia Yeomans)教授強調稱,自然界是非常神奇的,能夠制造微型發動機,如果我們深入理解和分析,它們將具有巨大的潛能。
